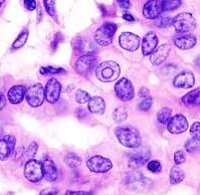

Другие названия и синонимы
Papillary adenocarcinoma of the kidney, Рак чашечно-лоханочной системы.
МКБ-10 коды
|
|
Описание
Папиллярная аденокарцинома почки. Гистологическая разновидность рака почки, поражающего почечную лоханку. Папиллярная почечная аденокарцинома проявляется гематурией, болью в пояснице, характер и интенсивность которой может достигать степени почечной колики; слабостью, похуданием. Диагностика рака лоханки требует проведения УЗИ почек, урографии, почечной ангиографии, КТ, радиоизотопной сцинтиграфии, МРТ. Радикальным оперативным объемом при папиллярной аденокарциноме почки является нефруретерэктомия; при диссеминации опухоли проводится химиотерапия.
Дополнительные факты
Папиллярная аденокарционома почки (рак почечной лоханки) урология диагностирует в 7-16% от всех случаев рака почки. Опухоль развивается из клеток переходного эпителия, выстилающего лоханку. Макроскопически папиллярная аденокарцинома имеет вид мягкого узлового образования, на разрезе приобретающего характерную пеструю окраску. При микроскопическом рассмотрении аденокарцинома имеет (сосочковую) папиллярную или тубулярную структуру. Как и рак паренхимы почки, папиллярная аденокарцинома чаще развивается у мужчин, достигая возрастного пика заболеваемости в 50-70 лет.
По распространенности первичной опухоли (T).
• Т0 - первичный очаг не выявляется.
• Tis - преинвазивная аденокарцинома in situ.
• Т1 - аденокарцинома прорастает субэпителиальный слой лоханки.
• Т2 - аденокарцинома прорастает мышечный слой лоханки.
• Т3 - аденокарцинома распространяется в окололоханочную клетчатку или почечную паренхиму.
• Т4 - аденокарцинома прорастает в стенки соседних органов или паранефральную клетчатку.
По наличию метастазов в регионарных лимфоузлах (паракавальных, парааортальных, в воротах печени) (N):
• N0 - в регионарных лимфоузлах метастазы отсутствуют.
• N1 - единичные метастазы в лимфоузлах до 2-х см в диаметре.
• N2 - единичные метастазы в лимфоузлах до 5 см в диаметре.
• N3 - метастазы в лимфоузлах более 5 см в диаметре.
По наличию отдаленных метастазов (M) в легких, костях, печени, головном мозге, плевре, брюшине:
• М0 - отсутствие данных за отдаленные метастазы.
• М1 - наличие данных за отдаленные метастазы.
Классификакция папиллярной аденокарциномы почки.
TNM-классификация выделяет следующие стадии папиллярной аденокарциномы почки.По распространенности первичной опухоли (T).
• Т0 - первичный очаг не выявляется.
• Tis - преинвазивная аденокарцинома in situ.
• Т1 - аденокарцинома прорастает субэпителиальный слой лоханки.
• Т2 - аденокарцинома прорастает мышечный слой лоханки.
• Т3 - аденокарцинома распространяется в окололоханочную клетчатку или почечную паренхиму.
• Т4 - аденокарцинома прорастает в стенки соседних органов или паранефральную клетчатку.
По наличию метастазов в регионарных лимфоузлах (паракавальных, парааортальных, в воротах печени) (N):
• N0 - в регионарных лимфоузлах метастазы отсутствуют.
• N1 - единичные метастазы в лимфоузлах до 2-х см в диаметре.
• N2 - единичные метастазы в лимфоузлах до 5 см в диаметре.
• N3 - метастазы в лимфоузлах более 5 см в диаметре.
По наличию отдаленных метастазов (M) в легких, костях, печени, головном мозге, плевре, брюшине:
• М0 - отсутствие данных за отдаленные метастазы.
• М1 - наличие данных за отдаленные метастазы.
Причины
Заболевание является полиэтиологическим. Определяющую роль в развитии папиллярной аденокарциномы могут играть генетические дефекты и наследственные заболевания. Риск развития рака лоханки почки увеличивается при длительном приеме анальгетиков, НПВП, мочегонных средств; воздействии ионизирующего излучения, никотина и алкоголя.
Трансформацию переходного эпителия почечных лоханок могут вызывать состояния иммунодефицита, длительное проведение гемодиализа, артериальная гипертензия, сахарный диабет, ожирение. У пациентов с папиллярной аденокарциномой почки в анамнезе нередко отмечается цистэктомия по поводу карциномы мочевого пузыря.
Трансформацию переходного эпителия почечных лоханок могут вызывать состояния иммунодефицита, длительное проведение гемодиализа, артериальная гипертензия, сахарный диабет, ожирение. У пациентов с папиллярной аденокарциномой почки в анамнезе нередко отмечается цистэктомия по поводу карциномы мочевого пузыря.
Клиническая картина
Папиллярная аденокарцинома почки протекает бессимптомно у 10-25 % пациентов. В большинстве случаев клиника манифестирует с тотальной гематурии (70-90% случаев), которая у трети больных сочетается с болевым синдромом в области поясницы. При обтурации мочеточника кровяным сгустком болевой приступ может протекать по типу почечной колики.
В 10% наблюдений имеет место классическая триада симптомов рака почки - гематурия, боль, пальпируемая опухоль. Обычно такое сочетание симптомом указывает на распространенность опухолевой инвазии и неблагоприятный прогноз. О далеко зашедшей стадии заболевания также свидетельствует похудание, слабость, субфебрилитет, артериальная гипертензия, анемия, нарушение аппетита.
Ассоциированные симптомы: Гематурия. Изменение аппетита. Изменение веса. Истощение. Ломота в мышцах. Лихорадка. Отсутствие аппетита. Потеря веса. Общая слабость.
В 10% наблюдений имеет место классическая триада симптомов рака почки - гематурия, боль, пальпируемая опухоль. Обычно такое сочетание симптомом указывает на распространенность опухолевой инвазии и неблагоприятный прогноз. О далеко зашедшей стадии заболевания также свидетельствует похудание, слабость, субфебрилитет, артериальная гипертензия, анемия, нарушение аппетита.
Ассоциированные симптомы: Гематурия. Изменение аппетита. Изменение веса. Истощение. Ломота в мышцах. Лихорадка. Отсутствие аппетита. Потеря веса. Общая слабость.
Диагностика
Распознавание папиллярной аденокарциномы почки нефрологом нередко затруднено. Проведение трехкратного цитологического исследования осадка мочи позволяет обнаружить атипичные клетки лишь в 30% случаев. Иногда для получения биоматериала прибегают к катетеризации мочеточника или забору промывных вод в процессе уретеропиелоскопии.
При экскреторной урографии папиллярная аденокарцинома определяется по дефекту заполнения почечной лоханки контрастным веществом, а при нарушении пассажа мочи - по признакам гидронефроза. Данные экскреторной урографии уточняются с помощью ретроградной уретеропиелографии, КТ почек с контрастным усилением, МСКТ, МРТ, сцинтиграфии. Почечная ангиография информативная при прорастании аденокарциномы в паренхиму почки и позволяет точно определить локализацию первичного очага (в лоханке или паренхиме).
Ценность УЗИ почек заключается в возможности выявления гидронефрротической трансформации, а также дифференциации рентгенонегативных камней почки и опухолей лоханки. Более информативные данные получают в ходе эндолюминальной эхографии: папиллярная аденокарцинома почки выявляется в виде эхопозитивного образования; также метод позволяет выяснить глубину инвазии опухоли в слои почечной лоханки.
Для исключения имплантационных метастазов в мочеточник и мочевой пузырь проводится эндоскопическое обследование мочевых путей - уретероскопия, цистоскопия, при необходимости - биопсия. Папиллярную аденокарциному дифференцируют с туберкулезом почки, пиелитом, нефролитиазом. При подозрении на отдаленные метастазы выполняется рентгенография легких, головного мозга, костей, УЗИ печени.
При экскреторной урографии папиллярная аденокарцинома определяется по дефекту заполнения почечной лоханки контрастным веществом, а при нарушении пассажа мочи - по признакам гидронефроза. Данные экскреторной урографии уточняются с помощью ретроградной уретеропиелографии, КТ почек с контрастным усилением, МСКТ, МРТ, сцинтиграфии. Почечная ангиография информативная при прорастании аденокарциномы в паренхиму почки и позволяет точно определить локализацию первичного очага (в лоханке или паренхиме).
Ценность УЗИ почек заключается в возможности выявления гидронефрротической трансформации, а также дифференциации рентгенонегативных камней почки и опухолей лоханки. Более информативные данные получают в ходе эндолюминальной эхографии: папиллярная аденокарцинома почки выявляется в виде эхопозитивного образования; также метод позволяет выяснить глубину инвазии опухоли в слои почечной лоханки.
Для исключения имплантационных метастазов в мочеточник и мочевой пузырь проводится эндоскопическое обследование мочевых путей - уретероскопия, цистоскопия, при необходимости - биопсия. Папиллярную аденокарциному дифференцируют с туберкулезом почки, пиелитом, нефролитиазом. При подозрении на отдаленные метастазы выполняется рентгенография легких, головного мозга, костей, УЗИ печени.
Лечение
При операбельном процессе показано выполнение нефруретерэктомии и резекции мочевого пузыря, что позволяет предупредить имплантационное распространение папиллярной аденокарциномы почки по мочевым путям. Меньший объем вмешательства (пиелотомия с удалением опухоли, резекция почки или тотальная нефрэктомия) могут привести к рецидиву аденокарциномы и генерализации процесса. Органосохраняющая тактика может быть оправдана при поражении единственной почки либо выраженной недостаточности функции почек.
Целесообразность выполнения лимфаденэктомии при неизмененных лимфоузлах остается предметом дискуссий, однако удаление лимфоузлов имеет значение для стадирования опухолевого процесса. При распространенном раке лоханки операция дополняется химиотерапией или лучевой терапией.
Целесообразность выполнения лимфаденэктомии при неизмененных лимфоузлах остается предметом дискуссий, однако удаление лимфоузлов имеет значение для стадирования опухолевого процесса. При распространенном раке лоханки операция дополняется химиотерапией или лучевой терапией.
Прогноз
Прогноз при папиллярной аденокарциноме почки определяется стадией процесса и степенью дифференцировки опухоли. Прогноз пятилетней выживаемости после радикальной нефруретерэктомии и резекции мочевого пузыря при неинвазивном росте переходноклеточной аденокарциномы составляет 75-90 %. При метастазировании или нерадикальной операции прогноз крайне неблагоприятный - выживаемость не превышает 2-3-х лет.
|
|